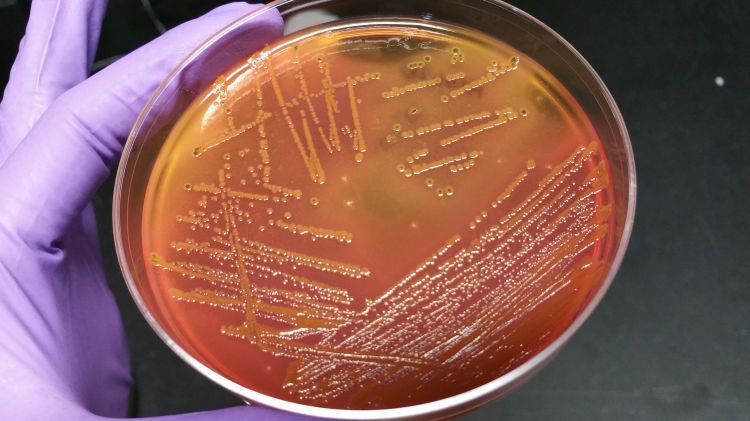

A highly multi-disciplinary team of Michigan State University scientists have designed a study to probe how the intestinal microbiome of dairy cattle affects antibiotic resistance, a problem plaguing farms across the country.
The project, which includes collaborators from the College of Natural Science (NatSci), the College of Agriculture and Natural Resources (CANR) and the College of Veterinary Medicine (CVM), is supported by a 4-year, $498,000 grant from the USDA’s National Institute of Food and Agriculture’s (NIFA) Agriculture and Food Research Initiative (AFRI).
“The emergence of bacterial populations that resist antibiotics commonly used in human and veterinary medicine is a major public health concern worldwide,” said Shannon Manning, MSU Foundation Professor in the NatSci Department of Microbiology and Molecular Genetics (MMG) and project lead. “This important study will reveal whether antibiotic infusions used to treat mastitis contribute to increases in the abundance of antibiotic resistant bacterial populations in the gut of dairy cattle.”
Using molecular biology and epidemiological and evolutionary methods, Manning’s lab has already written several key articles about studies that investigate the role of the intestinal microbiome in patients with diarrhea caused by E. coli and other bacteria.
“We use metagenomics, or the sequencing and analysis of the collective genomes of microbial communities in the gut, to figure out which communities are thriving in the presence of a pathogen, and which are not, in an effort to identify microbial markers for disease and identify how it affects the abundance of antibiotic resistance genes,” said Manning, who is also an MSU AgBioResearch scientist. “We are applying the same tools to analyze the data generated through this study.”
The lives of dairy cattle may be routine, but the life cycle of antibiotic resistant bacteria—its origin, selection and spread—is a multifaceted problem being tackled by this team of scientists, which includes expertise in cattle husbandry, animal science, microbiology, genomics, epidemiology and statistics.
Ceftiofur, a commonly used antibiotic on dairy farms to treat post-lactation mastitis, leaves residues of antibiotics that select for resistant bacteria capable of spreading into the farm environment and other animals, limiting effective options for treatment.
“Several studies have examined the impact of antibiotics on the milk microbiome in dairy cattle, but very few have examined how the commonly used antibiotic ceftiofur impacts the intestinal microbiome,” Manning said. “Findings from this study can help inform current treatment guidelines to minimize resistance and promote the judicious use of antibiotics.
“This project requires a collaborative multidisciplinary team of researchers,” Manning continued. “Each investigator adds an important piece to the study and working together is essential for accomplishing our goals.”
For example, team member Lixin Zhang is an expert in understanding how antibiotic resistant genes are transmitted and move within bacterial populations.
“My role is to oversee the transmission network analysis using both genomic and epidemiological data in order to quantify the spread of resistance within and between cattle,” said Zhang, an MSU assistant professor with joint appointments in the Departments of Microbiology and Molecular Genetics (NatSci) and Epidemiology and Biostatistics in the College of Human Medicine. “In addition to selection pressure by antibiotics, transmission can greatly contribute to the increase of resistance.”
In addition to Manning and Zhang, other MSU scientists participating in the project are: Pamela Ruegg, professor and chair, CANR Department of Animal Science, and three faculty members who hold joint appointments in CANR and CVM: Ron Erskine, professor of large animal clinical sciences; Bo Norby, associate professor of large animal clinical sciences; and Lorraine Sordillo-Gandy, Meadow Brook Chair in Farm and Animal Health and Wellbeing and professor of large animal clinical sciences. Erskine, Norby and Sordillo-Gandy are also AgBioResearch faculty members.



 Print
Print Email
Email




